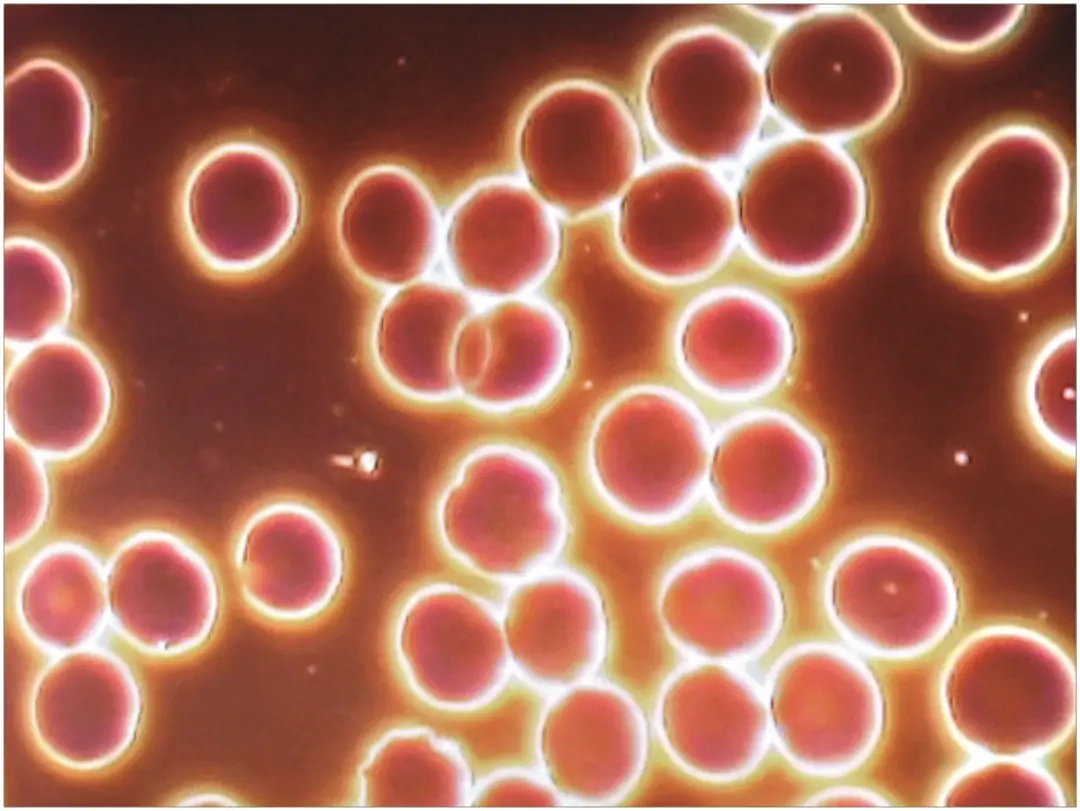
Sangre humana con Bio Music One

Pruebas sonoras de Bio Music One
Desde hace más de veinte años, Bio Music One ha sido objeto de pruebas, análisis y observaciones experimentales en diferentes contextos: agua, sangre humana, coherencia cardíaca, electrofisionía, actividad cerebral, geobiología y bienestar global.
Esta página presenta una síntesis clara de las principales áreas documentadas hasta ahora.
🔬 Lo que descubrirás en esta página
Los elementos reunidos aquí provienen de distintos participantes y de diferentes métodos de observación. Destacan posibles efectos relacionados con la estructuración del agua, el equilibrio de los seres vivos, la reducción del estrés, la vitalidad y el entorno.
Esta página web es una versión sintética. Un informe PDF más completo puede descargarse al final de la página.
✨ Principales áreas tratadas en el informe
- Agua y medio acuoso : cristales de agua congelada, reestructuración, conductividad, refractometría, espectrometría
- Sangre humana : observaciones microscópicas antes y después de la exposición a diferentes entornos
- Electrofisionía : agua, cuerpo humano, plantas, estrés y perturbaciones electromagnéticas
- Cristalización sensible : evolución de muestras orgánicas durante varias semanas
- Funciones fisiológicas : vitalidad, equilibrio global, parámetros del organismo
- Actividad cerebral : biorritmos cerebrales y actividad eléctrica del cerebro
- Estrés y coherencia cardíaca : calma, regulación, estabilidad
- Entorno y sistemas vivos : geobiología, Feng Shui, plantas, ambiente de vida
💧 Cristales de agua congelada
Pruebas atribuidas a los laboratorios de Masaru Emoto muestran una diferencia visual entre agua de control y agua expuesta a varios álbumes de Bio Music One.


🩸 Pruebas sobre sangre humana
Se presentaron observaciones con microscopía de campo oscuro para comparar el estado de la sangre antes de la exposición a campos electromagnéticos, después de la exposición, y posteriormente con la difusión de Bio Music One.

⚡ Proceso electrofisionico
Los documentos presentan varias series de imágenes atribuidas a Georges Hadjo relativas al agua, al cuerpo humano, a las plantas y a la exposición a la contaminación electromagnética.




❄️ Cristalización sensible
Cinco estudios atribuidos a Marie-Françoise Tesson presentan más de 110 imágenes de cristalización sensible durante varias semanas utilizando diferentes muestras orgánicas.


📈 Reestructuración y conductividad del agua
Varios estudios atribuidos a Mikhail Kulagin se centran en el estado estructural del medio acuoso bajo la influencia de Bio Music One.

- Efecto reestructurante destacado en el medio acuoso
- Optimización de la conductividad del agua en las conclusiones citadas
- Neutralización descrita de una influencia perturbadora procedente de un ordenador portátil
🧠 Funciones del organismo y actividad cerebral
Los documentos también mencionan un conjunto de pruebas sobre las funciones del organismo, los biorritmos cerebrales y la actividad eléctrica del cerebro.


💛 Estrés, vitalidad y coherencia cardíaca
Varias líneas convergen en esta dimensión: coherencia cardíaca, biorritmos cerebrales, actividad eléctrica cerebral, observaciones sobre el campo informacional... Abajo, pruebas del Dr Christian Roche y de la Dra Pascale Miniou sobre estrés, vitalidad y equilibrio general.




🌍 Entorno, geobiología y sistemas vivos
Más allá del bienestar humano, los documentos también mencionan observaciones sobre plantas, geobiología, campos de torsión, el entorno del hogar y lecturas de Feng Shui.
📘 Cómo leer estos resultados
Esta página reúne elementos procedentes de documentos históricos y de síntesis. Su principal interés reside en la convergencia de las áreas observadas: agua, estrés, equilibrio, vitalidad, entorno.
- Se trata de una síntesis web, no de un informe exhaustivo
- La redacción se ha hecho más accesible para el público general
📥 Descargar el informe de pruebas
Un informe resumido más completo de las pruebas está disponible para descarga en formato PDF (Versión francesa de momento).




